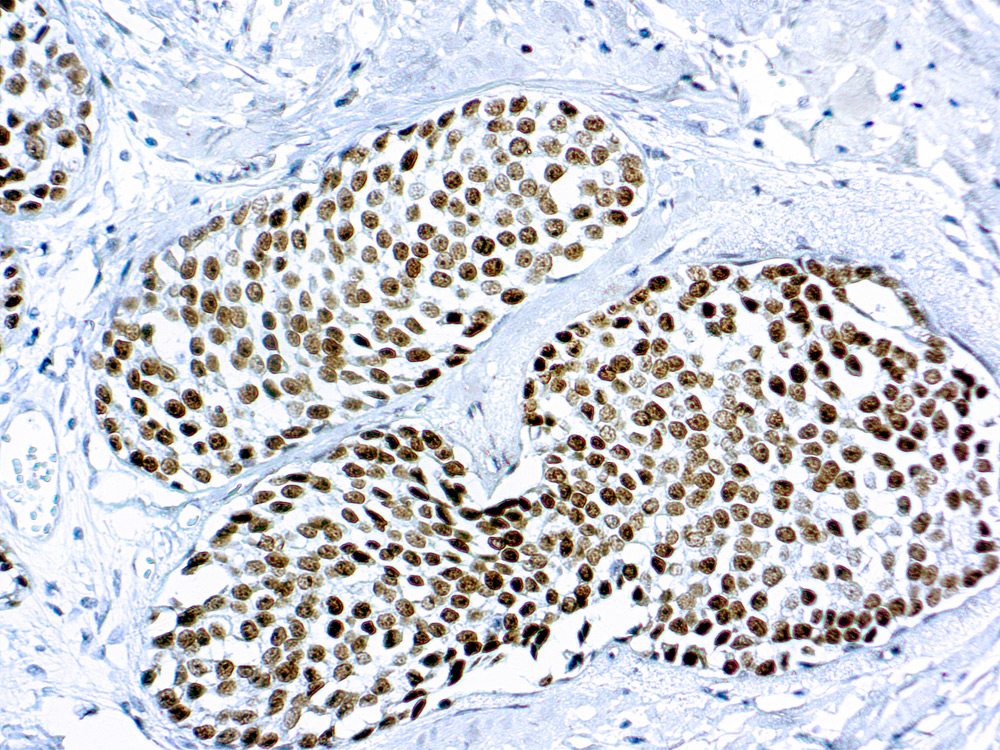

GATA3 binding protein 3 or GATA3, is a zinc finger transcription factor and plays an important role in promoting and directing cell proliferation,
development, and differentiation in many tissues and cell types. The human GATA3 gene has been mapped to chromosome 10p15. GATA =3
expression is primarily seen in breast carcinoma and urothelial carcinoma. Anti-GATA3 can also be useful in the identification of unknown primary
carcinoma when carcinomas of the breast or bladder are a possibility.
1.0 ml
| Clone | L50-823 |
| Application | IHC |
| Host | Mouse |
La documentación estará disponible en breve, mientras tanto, puede contactarnos por correo electrónico a specialist@histoline.com